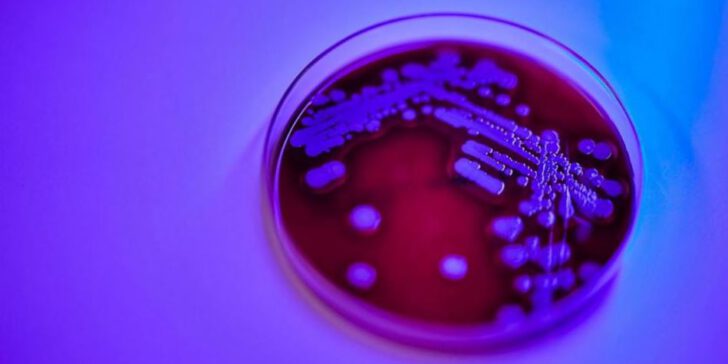

অনলাইন ডেস্ক :
সিঙ্গাপুরের চিকিৎসকরা ত্বকে উৎপন্ন ব্যাকটেরিয়ার এক প্রজাতি উদ্ভব করেছেন। ত্বকের ক্ষতের নমুনা থেকে এই ব্যাকটেরিয়ার উদ্ভব করেছে তারা।
তবে শুধু এই ব্যাকটেরিয়ার উদ্ভব করেই শেষ না নিজেদের দেশের নামেই রেখেছেন ব্যাকটেরিয়ার নাম। নতুন প্রজাতির এই ব্যাকটেরিয়ার নাম ‘সিঙ্গাপুর।’
গত ২৬ অক্টোবর ইন্টারন্যাশনাল জার্নাল অফ সিস্টেম্যাটিক অ্যান্ড ইভোলিউশনারি মাইক্রোবায়োলজি সাময়িকীতে এ গবেষণা প্রকাশিত হয়েছে।
নতুন ব্যাকটেরিয়া সিঙ্গাপুর হলো স্ট্যাফিলোকোকাস অ্যারিয়াসের একটি অংশ যার ফলে ত্বকে ইনফেকশন থেকে শুরু থেকে রক্তে মারাত্মক ইনফেকশন হতে পারে এবং এ থেকে হতে পারে মৃত্যু।
সিঙ্গাপুর ব্যাকটেরিয়াকে আলাদাভাবে চিহ্নিত করতে ন্যাশনাল ইউনিভার্সিটি হসপিটাল, ন্যাশনাল সেন্টার ফর ইনফেকশাস ডিজিজ, সিঙ্গাপুর জেনারেল হসপিটাল ২০১৯ সালের এপ্রিল থেকে জুলাই ২০২০ পর্যন্ত ব্যাকটেরিয়ার বিচ্ছিন্নতা নিয়ে গবেষণা করেছেন যার সাথে এস অরিয়াসের সাথে সম্পর্ক আছে।
সবগুলোর জেনোম সিকুয়েন্স করে দেখা গেছে যে, ৪৩ টার মধ্যে ৬টা অন্যান্য প্রজাতির চেয়ে ভিন্ন। আর ওই ৬টিকেই নতুন প্রজাতি হিসেবে চিহ্নিত করা হয়েছে যা হলো সিঙ্গাপুর ব্যাকটেরিয়া।
ন্যাশনাল সেন্টার ফর ইনফেকশাস ডিজিজের ন্যাশনাল পাবলিক হেলথ ল্যাবরেটরির পরিচালক সহযোগী অধ্যাপক রেমন্ড লিন বলেন, যেকেউ জীবনের যেকোন পর্যায়ে এই ব্যাকটেরিয়ার মাধ্যমে আক্রান্ত হতে পারে।
দীর্ঘদিন ধরে রয়েছে নতুন এই ব্যাকটেরিয়ার প্রজাতি এবং কেউ আগে লক্ষ্য করেনি। ব্যাকটেরিয়ার নতুন এই প্রজাতি কিছু অ্যান্টিবায়োটিকের মাধ্যমে প্রতিরোধ করা যায় যেমন এস অরিয়াসও ছিল ওষুধ প্রতিরোধী। সিঙ্গাপুর ব্যাকটেরিয়ায় টক্সিনের অভাব রয়েছে যা এস অরিয়াসে ছিল।
নতুন প্রজাতি চিহ্নিত করা বিজ্ঞানীদের এর সম্পর্কে আরো বিশ্লেষণ করতে সাহায্য করবে বলে মত অধ্যাপক লিন।
সূত্র: দ্য স্ট্রেইট টাইমস।
















